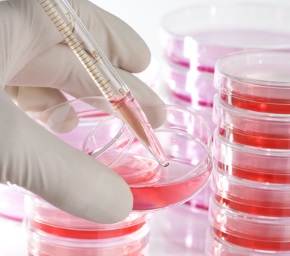

Терапевтические отделения
ГАСТРОЭНТЕРОЛОГИЧЕСКОЕ ОТДЕЛЕНИЕ
(+375 222) 62-97-87
В отделении оказывается помощь пациентам с различной патологией органов пищеварения, требующей стационарного обследования и лечения.
ГЕМАТОЛОГИЧЕСКОЕ ОТДЕЛЕНИЕ
(+375 222) 63-26-40
В отделении оказывается помощь пациентам с гематологическими и онкологическими заболеваниями, заболеваниями системы крови.
КОНСУЛЬТАЦИОННОЕ КАРДИОЛОГИЧЕСКОЕ ОТДЕЛЕНИЕ
(+375 222) 63-03-25
Предварительная запись на консультацию врача-кардиолога осуществляется в регистратуре консультационного кардиологического отделения при личном обращении или по телефону с 7.30 до 19.00 (понедельник — пятница).
КАРДИОЛОГИЧЕСКОЕ ОТДЕЛЕНИЕ ДЛЯ ЛЕЧЕНИЯ ПАЦИЕНТОВ С ИНФАРКТОМ МИОКАРДА
(+375 222) 40-04-23
В отделении оказывается высококвалифицированная помощь пациентам, страдающим сердечно-сосудистыми заболеваниями.
КАРДИОЛОГИЧЕСКОЕ ОТДЕЛЕНИЕ №2 (ДЛЯ БОЛЬНЫХ С НАРУШЕНИЕМ РИТМА СЕРДЦА)
(+375 222) 40-04-15
В отделении оказывается высококвалифицированная помощь пациентам, страдающим сердечно-сосудистыми заболеваниями.
КАРДИОЛОГИЧЕСКОЕ ОТДЕЛЕНИЕ №3 (ЭКСПЕРТНО-ДИАГНОСТИЧЕСКОЕ)
(+375 222) 40-04-03
В отделении оказывается высококвалифицированная помощь пациентам, страдающим сердечно-сосудистыми заболеваниями.
4-ОЕ КАРДИОЛОГИЧЕСКОЕ ОТДЕЛЕНИЕ (СЕРДЕЧНОЙ НЕДОСТАТОЧНОСТИ)
(+375 222)
(+375 222)
Кардиологическое отделение развернуто на 40 коек. Пациенты размещаются в одно- и двухместных палатах. Во всех палатах имеется санузел, душ, холодильник.
ПРИЕМНОЕ ОТДЕЛЕНИЕ
(+375 222) 68-01-86
Круглосуточно в «Могилевской областной больнице» оказывается экстренная медицинская помощь, включая интенсивную терапию и реанимацию.
ЭНДОКРИНОЛОГИЧЕСКОЕ ОТДЕЛЕНИЕ
(+375 222) 63-60-67
На базе отделения осуществляется высококвалифицированная специализированная помощь пациентам со всей эндокринной патологией.
НЕВРОЛОГИЧЕСКОЕ
ОТДЕЛЕНИЕ
(+375 222) 63-57-88
В отделении обследуются пациенты с заболеваниями ЦНС, ПНС, неврозами, с подозрением на аневризмы сосудов головного мозга.
ОТДЕЛЕНИЕ ГЕМОДИАЛИЗА И НЕФРОЛОГИИ
(+375 222) 62-96-23
Отделение оказывает помошь пациентам с заболеваниями почек и осуществляет перитонеальный диализ.
ТЕРАПЕВТИЧЕСКОЕ ОТДЕЛЕНИЕ для ветеранов ВОВ и лиц к ним приравненных
(+375 222) 62-83-95
Отделение оказывает помошь ветеранам войн и лицам, пострадавшим от последствий войн, пожилым гражданам